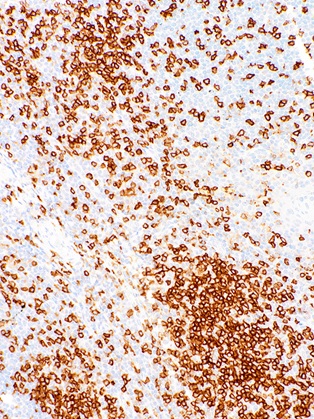

CD45RO Mouse Monoclonal Antibody(ARM953)
CAT.NO. : ARM6743
RMB Please choose
RMB Please choose
Size:
Trail, Bulk size or Custom requests Please contact us
*产品价格可能会有所调整,请以品牌方官网实时更新的价格为准,以确保准确性。
Background
CD45RO is an isoform of CD45 which is expressed in thymocytes, activated T-cells, and subpopulations of resting T-cells. It is a useful marker for T-cell tumours, as Anti-CD45RO demonstrates no reactivity with B-cells. Specifically, CD45RO is implicated in a number of T-cell lymphomas including angioimmunoblastic, lymphoblastic, peripheral, and subcutaneous panniculitis-like T-cell lymphomas.
Application
|
Application |
Dilution Ratio |
|
IHC |
1:50 - 1:200 |
Overview
|
Molecular Weight |
147,254 Da |
|
Chromosome Location |
Chromosome: 1; NC_000001.10 (198608098..198726605). Location: 1q31-q32 |
|
3D Structure |
ModBase 3D Structure for P08575 |
|
Isotype |
IgG2a |
|
Host |
Mouse |
|
Species Reactivity |
Human |
|
Purity/Purification |
Purified |
|
Form/Format |
Tris Buffer, pH 7.3 - 7.7, with 1% BSA and <0.1% Sodium Azide |
|
Immunogen |
Recombinant Protein |
Data
Immunohistochemical staining of human tonsil tissue using CD45RO Mouse Monoclonal Antibody (ARM953).
Storage
Store at 4°C short term. For long term storage, store at -20°C, avoiding freeze/thaw cycles.
Research Use Only
For Research Use Only. Not for use in diagnostic procedures.
New Products
